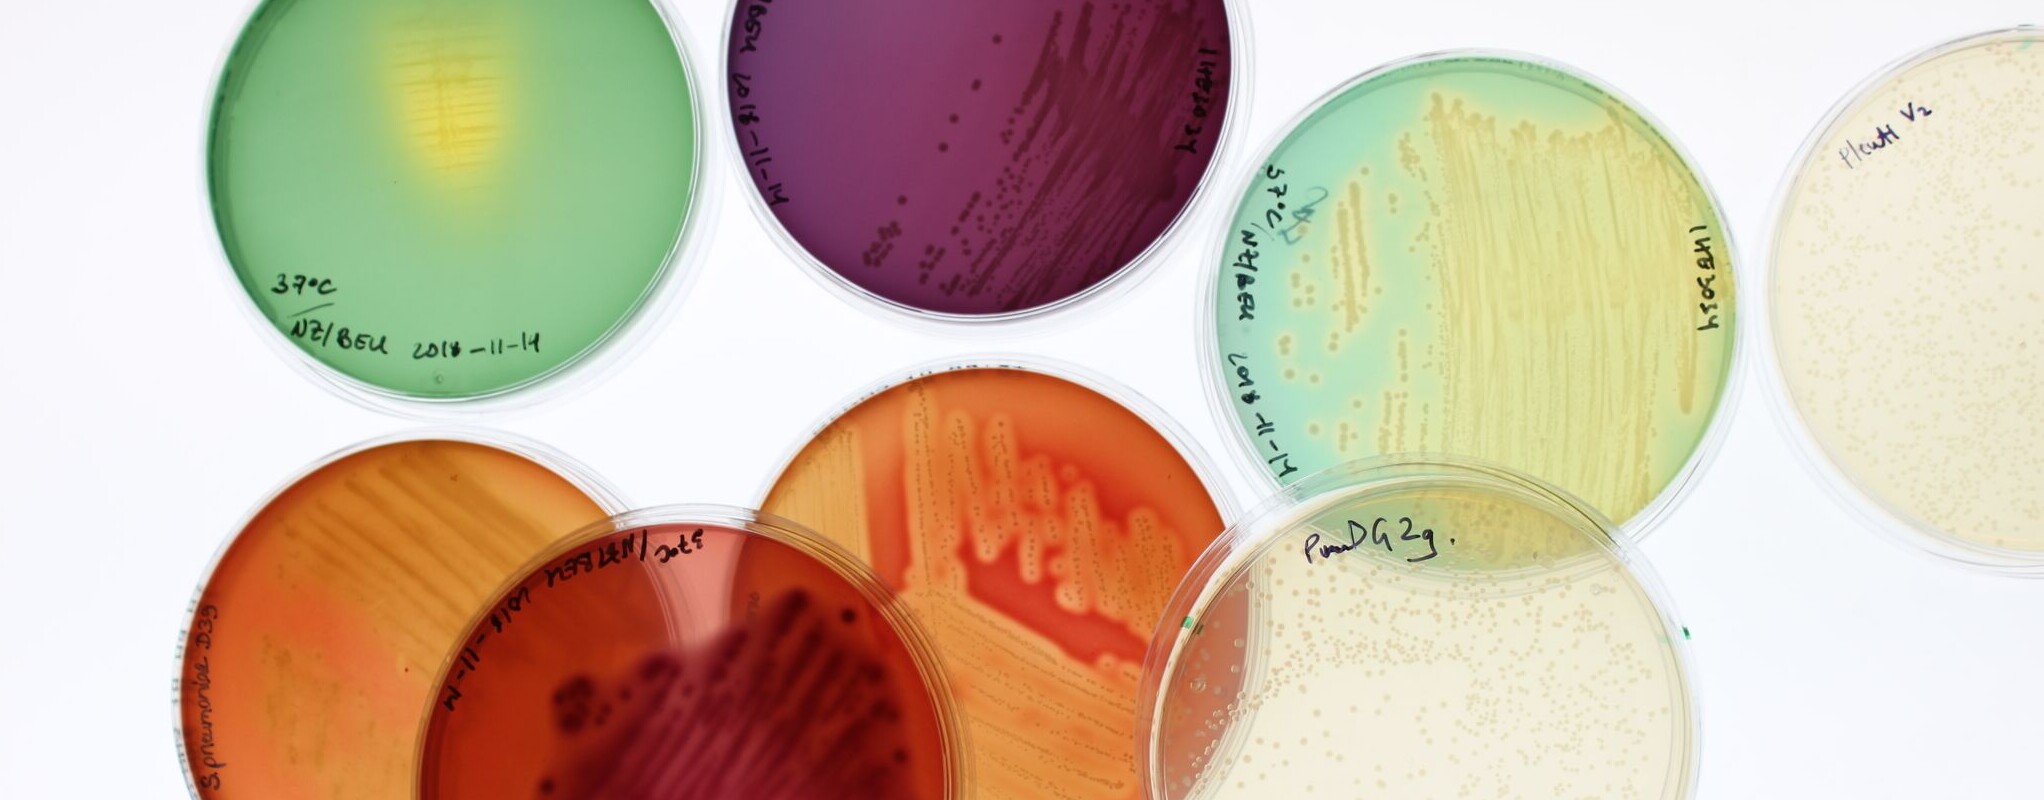

Image: Nikola Zlatkov Kolev
Right now you are surfing a limited version of umu.se. What does this mean?
Image: Nikola Zlatkov Kolev
Infection biology is a research area that covers the pathways whereby pathogens (viruses, bacteria, fungi, and parasites) transmit between hosts, the mechanisms whereby these pathogens infect and colonise cells, tissues, and organs, and the mechanisms whereby pathogens cause disease in humans, animals and plants. The area also covers research performed with the intention to develop novel treatments, vaccines, and to tackle the problems with drug resistance.

New antibacterial substances are being identified that can impair bacterial pathogenicity.

Virology in Umeå is concerned with every aspect of viruses.

Parasites are a broad group of organisms that cause everything from deadly diseases to harmless diseases.

Inefficient diagnostics and therapeutics with toxic side effects urge us to develop better antifungal drugs.

The applied research focuses on the development of drugs against viral infections and vaccine research.

Antimicrobial resistance is a global public health problem that is increasing at an alarming rate.

Chemistry professor represents Umeå University in the Royal Swedish Academy of Engineering Sciences, IVA.

Three researchers have been appointed Wallenberg Academy Fellows by the Knut and Alice Wallenberg Foundation.

Meet Sanja Vanhatalo, a postdoc in Björn Schröder's lab who studies microbiota and inflammatory bowel disease.

COVID-19 research is a priority and urgent at Umeå University.